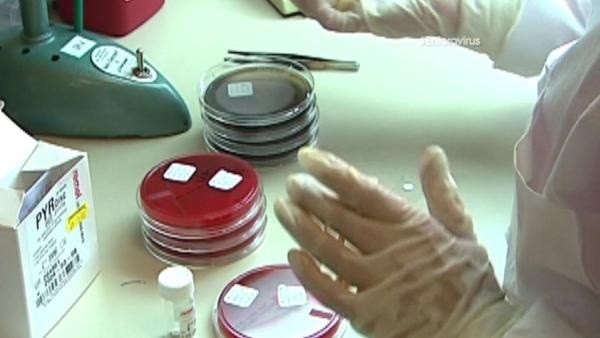
Lab Specimens

MEDIA RELEASE
From the Office of theCommissioner of Health, Dr. Gale R. Burstein
Date September 22, 2014
CONTACT: Mary C. St. Mary/Mary.StMary@Erie.Gov
Phone: 716.858.4941/ Mobile: 716.253.3925
Presence of Enterovirus EV-D68 Confirmed in WNY
Erie County Specimens Test Positive for Virus Strain
ERIE COUNTY, NY— At a press conference held earlier today at Women & Children’s Hospital of Buffalo, the Erie County Department of Health (“ECDOH”) confirmed the presence of Enterovirus EV-D68 in Erie County.
“As expected, some of the samples sent to the Wadsworth Center, New York State’s Public Health Laboratory in Albany tested positive for Enterovirus EV-D68” stated Dr. Gale R. Burstein, Erie County Commissioner of Health. “We anticipate that additional specimens will be found to be positive for the Enterovirus EV-D68 as they are tested.”
For most ch ildren, adolescents, and adults, this virus presents as the common cold. Symptoms may include fever, runny nose, sneezing and coughing although most individuals with the EV-D68 virus will exhibit only mild symptoms. However, certain individuals, particularly children with chronic lung disease, such as asthma, may require hospitalization.
ildren, adolescents, and adults, this virus presents as the common cold. Symptoms may include fever, runny nose, sneezing and coughing although most individuals with the EV-D68 virus will exhibit only mild symptoms. However, certain individuals, particularly children with chronic lung disease, such as asthma, may require hospitalization.
Erie County residents are urged to follow these precautions to prevent the spread of the EV-D68 virus:
- Wash hands often with soap and water for a minimum of 20 seconds
- Avoid touching eyes, nose and mouth with unwashed hands
- Avoid kissing, hugging, and sharing food, drink, eating utensils or beverage glasses with people who are sick
- Use disinfectant on frequently touched surfaces such as toys, doorknobs, shared telephones, and countertops, especially if someone is already ill
Burstein concluded: “Frequent hand-washing is the most important health tip for all of us to remember so that we do not spread illness. Wash your hands carefully and thoroughly with soap and water, especially after using the toilet or changing diapers, and always before eating, preparing, or handling food. When sneezing or coughing, be sure to turn away from others and use a tissue to cover your mouth or nose and sneeze into the crook or your arm, rather than into your hands.”
# # #
For More Information:
Erie County Department of Health – www.erie.gov/health
NY State Department of Health -- http://www.health.ny.gov/press/releases/2014/2014-09-10_monitoring_respiratory_virus.htm
http://www.health.ny.gov/press/releases/2014/2014-09-12_ev-d68_confirmed.htm
Centers for Disease Control and Prevention –
http://www.cdc.gov/non-polio-enterovirus/about/EV-D68.html
http://www.cdc.gov/non-polio-enterovirus/about/EV-D68.html?s_cid=cdc_homepage_whatsnew_001
